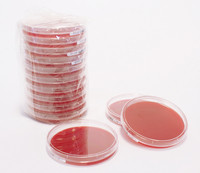

| Tên sản phẩm: | Columbia Blood Agar Pharm 100PC Merck |
| Tên gọi khác: | Columbia Agar |
| Code: | 1465590100 |
| Hãng – Xuất xứ: | Merck – Đức |
| Ứng dụng: |
– Được sử dụng rộng rãi trong phòng thí nghiệm trường học, viện nghiên cứu,.. – Được dùng để tăng sinh và cô lập một lượng lớn các loài vi sinh, đặc biệt là các khuẩn khó tính: streptococci và pneumococci trong các mẫu động vật |
| Tính chất: |
– Hình thể: dạng gel – Màu sắc: màu đỏ – Gía trị pH: 7.3 (H₂O) |
| Bảo quản: | Từ +15°C đến +25°C |
| Quy cách: | 100 tấm/ hộp |
Sản phẩm tham khảo:
| Code | Quy cách |
| 1465590020 | 20 tấm/ hộp |
| 1465590100 | 100 tấm/ hộp |

Đánh giá
Chưa có đánh giá nào.